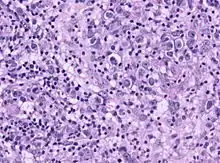

Герминома
Герминома (germinoma; лат. germen, germinis росток, зародыш + -ома) — это дизонтогенетическая опухоль, локализующаяся как правило в глубинных структурах головного мозга. Может быть как доброкачественной так и злокачественной.
| Герминома | |
|---|---|
| МКБ-О | 9060-9061, M9064/3 |
| MeSH | D018237 |

Причины возникновения
Герминома возникает в процессе нарушения эмбрионального развития плода. Данная теория не имеет официального подтверждения, однако, молодой возраст пациентов с данной патологией подтверждает состоятельность этой теории.
Данная опухоль является следствием расстройства тканевой дифференцировки и миграции тканей на ранних этапах развития эмбриона.
К факторам, провоцирующим эти нарушения, можно отнести воздействие радиации на организм матери, интоксикацию лекарственными и иными веществами, влияние канцерогенных и токсических веществ, инфекционные поражения (тяжелые формы гриппа, корь, герпес, хламидиоз)[1].
Гистология
Опухоль однородна по внешнему виду, состоит из двух видов клеток: крупных клеток (являются истинными опухолевыми) с везикулярными ядрами и прозрачной или мелкозернистой цитоплазмой, которая является эозинофильной. Мелкие клетки, располагающиеся в кластерах или хаотично смешаны с опухолевыми клетками[2]. Микроскопическое исследование выявляет однородные клетки, которые напоминают первичные зародышевые клетки. Как правило, строма содержит лимфоциты, и около 20 % пациентов имеют саркоидоподобные гранулемы. Иммуногистохимический метод исследования определяет, что более 70 % лимфоцитов представлены Т-лимфоцитами, остальное приходится на В-лимфоциты.
Герминомы, содержащие гигантские синцитиотрофобластные клетки были отнесены в отдельную группу (К. Sano)[3].
Классификация
Чаще всего термин «герминома» относят к опухоли головного мозга, однако по гистологическим исследованиям она идентична дисгерминоме в яичнике и семиноме в яичке (семеннике). С 1994 года MeSH определяет герминому как «злокачественное новообразование зародышевой ткани половой железы (гонад), средостения или области шишковидной железы (тела)»[4].
Диагностика
При диагностике гермином, как и при диагностики других опухолей головного мозга, основными показателями являются клинические проявления:
- распирающая головная боль;
- тошнота;
- рвота;
- судорожные припадки,
- потеря аппетита,
- депрессия;
- снижение веса;
- слабость;
- нарушение памяти[1].
На основании этих проявлений, врач проводит исследования крови, компьютерную томограмму, МРТ, эхо-энцефалографию.
Герминома, среди всех опухолей мозга, занимает лишь 2 %, диагностируется в возрасте 10-12 лет, реже к 20 годам. Этому заболеванию подвержены чаще мужчины[5]. При диагностики данного заболевания, характерны симптомы гипофизарно-гипоталамической недостаточности (замедление роста, гипопитуитаризм, несахарный диабет). При исследовании с помощью рентгена данная опухоль может не определяться, особенно на ранних стадиях. При лабораторных исследованиях часто тестируются сывороточные и спинномозговые опухолевые маркеры альфа-фетопротеина (АФП) и бета-ХГЧ. Истинные герминомы не связаны с этими маркерами. Нергерминоматозные опухоли могут быть связаны с повышенными маркерами, такими как AFP, с эмбриональными клеточными карциномами и незрелыми тератомами и бета-ХГЧ, которые встречаются при хориокарциномах. У 1 до 15 % гермином может быть получен низкий уровень бета-ХГЧ. HCG-секретирующие герминомы могут быть более агрессивными, чем несекретирующие.
Локализация при расположении в головном мозге :
- шишковидное тело;
- перекрест зрительных нервов;
- гипоталамус;
- третий желудочек;
- гипофиз;
- область основания.
Лечение
Труднодоступное расположение герминомы затрудняет доступ нейрохирургам для удаления этого вида опухоли. В настоящее время для миниинвазивного лечения используют Кибер-нож или Гамма-нож (стереотаксическая радиохирургия). Так как лучевая терапия негативно влияет на не сформировавшийся детский организм, для лечения часто используют полихимиотерапию. При комплексном подходе также применяется и химиотерапия (цисплатин, блеомицин, винбластин, цисплатин и этопозид)[3].
Прогноз
Своевременное лечение дает неплохие прогнозы на выздоровление: средняя выживаемость пациентов в течение пяти лет составляет 75-90 %, после постановки диагноза. Ранняя диагностика и начало лечения повышают вероятность успеха.
Литература
- Малая медицинская энциклопедия. — М.: Медицинская энциклопедия. 1991—96 гг.
- Sadler, T.W. 2006. Langman’s medical Embryology, 10th Edition, Chapter 15, pp. 251—252. Lippincott, Williams & Wilkins, Pub.
- Keene D, Johnston D, Strother D, et al. (2007). «Epidemiological survey of central nervous system germ cell tumors in Canadian children». J. Neurooncol. 82 (3): 289-95.
- Balmaceda C, Heller G, Rosenblum M, et al. (1996). «Chemotherapy without irradiation--a novel approach for newly diagnosed CNS germ cell tumors: results of an international cooperative trial. The First International Central Nervous System Germ Cell Tumor Study». J. Clin. Oncol. 14 (11): 2908-15
- Ueba T, Yamashita K, Fujisawa I, et al. (2007). «Long-term follow-up of 5 patients with intracranial germinoma initially treated by chemotherapy alone». Acta Neurochirurgica. 149 (9): 897—902, discussion 902
- https://meshb.nlm.nih.gov/record/ui?name=Germinoma
Примечания
- Герминома головного мозга: симптомы, причины возникновения, лечение и профилактика. Онкология.ру (27 июля 2018). Дата обращения: 21 апреля 2020.
- Герминоклеточная опухоль мозга (герминома) - патология, морфология. meduniver.com. Дата обращения: 8 мая 2020.
- Герминома головного мозга - клиника, диагностика, лечение. medbe.ru. Дата обращения: 24 апреля 2020.
- MeSH Browser. meshb.nlm.nih.gov. Дата обращения: 22 апреля 2020.
- Герминома головного мозга. mrt-v-msk.ru. Дата обращения: 27 апреля 2020.